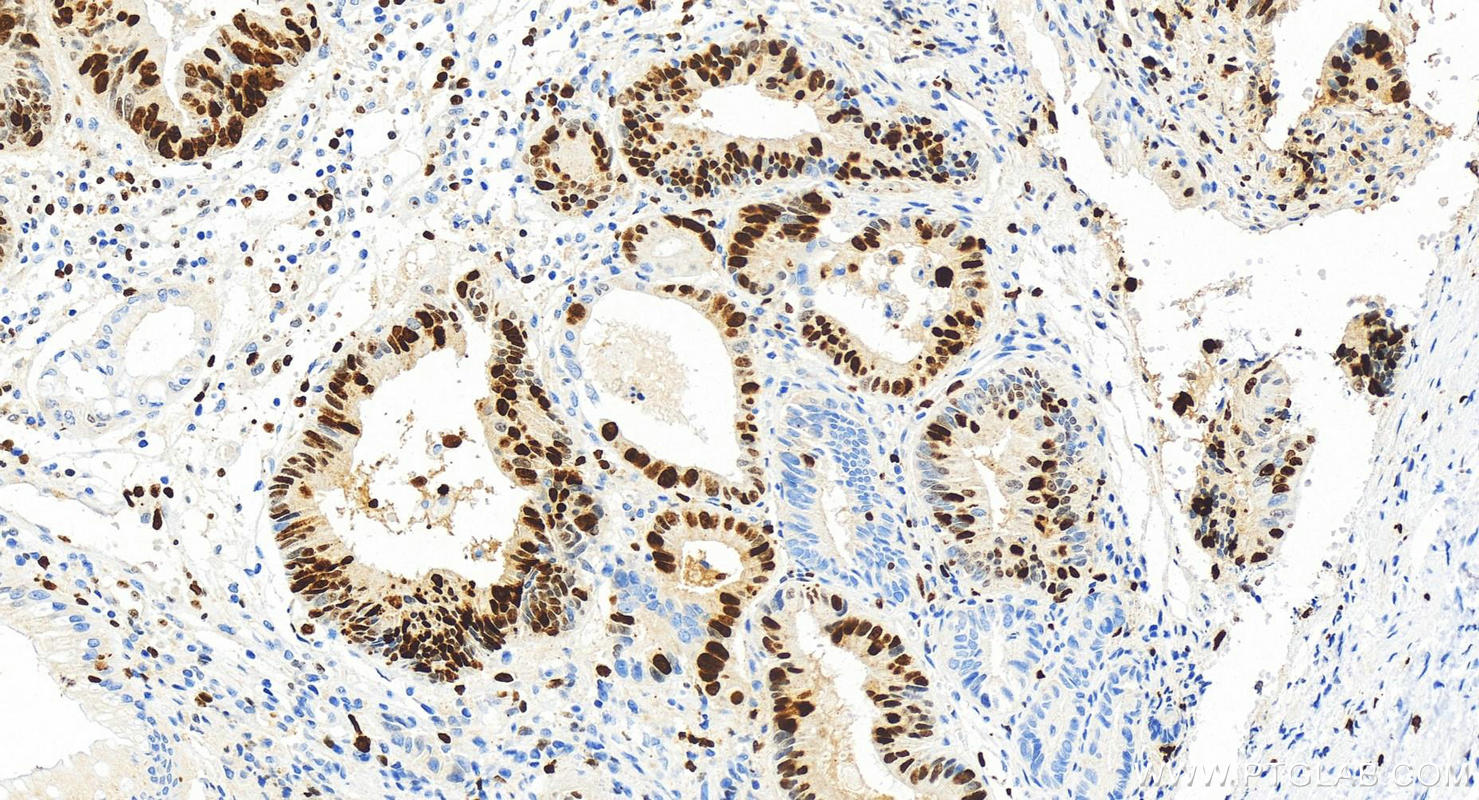

验证数据展示
发表文章中的应用
| IHC | See 1 publications below |
产品信息
84192-3-RR targets Ki-67 in IHC, ELISA applications and shows reactivity with human samples.
| 经测试应用 | ELISA Application Description |
| 文献引用应用 | IHC |
| 经测试反应性 | human |
| 文献引用反应性 | mouse |
| 免疫原 |
Peptide 种属同源性预测 |
| 宿主/亚型 | Rabbit / IgG |
| 抗体类别 | Recombinant |
| 产品类型 | Antibody |
| 全称 | antigen identified by monoclonal antibody Ki-67 |
| 别名 | KI67, MKI67, 241499B1, Antigen identified by monoclonal antibody Ki-67, Antigen KI-67 |
| 计算分子量 | 359 kDa |
| GenBank蛋白编号 | NM_002417 |
| 基因名称 | KI67 |
| Gene ID (NCBI) | 4288 |
| 偶联类型 | Unconjugated |
| 形式 | Liquid |
| 纯化方式 | Protein A purification |
| UNIPROT ID | P46013 |
| 储存缓冲液 | PBS with 0.02% sodium azide and 50% glycerol, pH 7.3. |
| 储存条件 | Store at -20°C. Stable for one year after shipment. Aliquoting is unnecessary for -20oC storage. |
背景介绍
The Ki-67 protein (also known as MKI67) is a cellular marker for proliferation. Ki67 is present during all active phases of the cell cycle (G1, S, G2 and M), but is absent in resting cells (G0). Cellular content of Ki-67 protein markedly increases during cell progression through S phase of the cell cycle. Therefore, the nuclear expression of Ki67 can be evaluated to assess tumor proliferation by immunohistochemistry. It has been demonstrated to be of prognostic value in breast cancer. In head and neck cancer, several studies have reported an association between high proliferative activity and poorer prognosis.
实验方案
| Product Specific Protocols | |
|---|---|
| IF protocol for Ki-67 antibody 84192-3-RR | Download protocol |
| IHC protocol for Ki-67 antibody 84192-3-RR | Download protocol |
| WB protocol for Ki-67 antibody 84192-3-RR | Download protocol |
| Standard Protocols | |
|---|---|
| Click here to view our Standard Protocols |